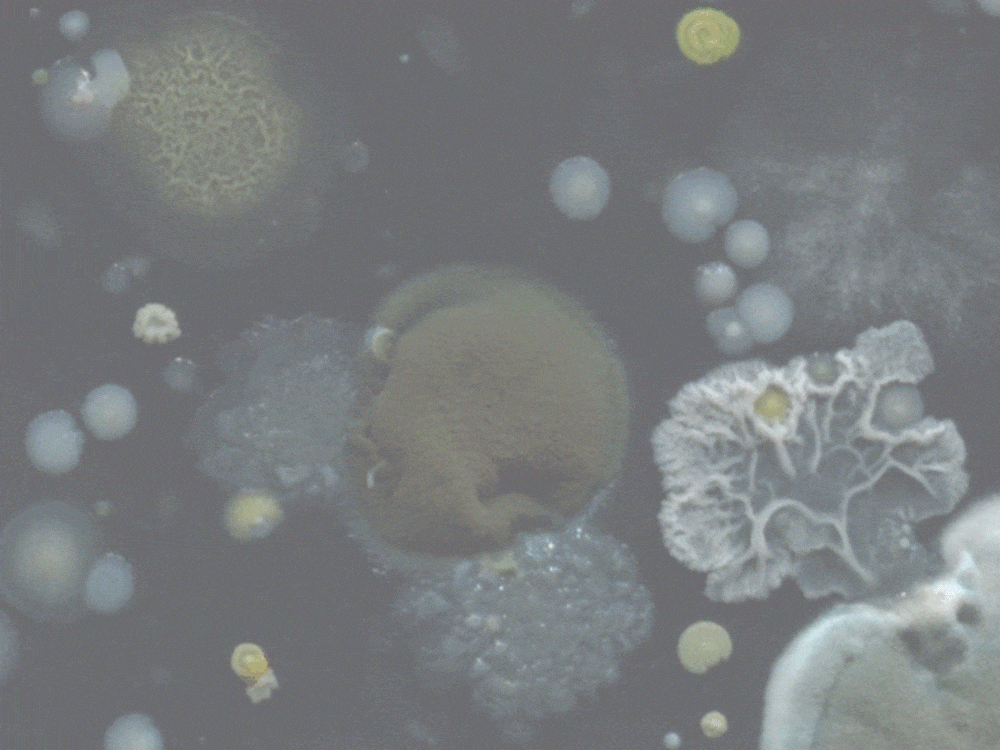
img

{{ 'fb_in_app_browser_popup.desc' | translate }} {{ 'fb_in_app_browser_popup.copy_link' | translate }}
{{ 'in_app_browser_popup.desc' | translate }}
VIP會員買滿$699即免順豐智能櫃運費✨
{{ childProduct.title_translations | translateModel }}
{{ getChildVariationShorthand(childProduct.child_variation) }}
{{ getSelectedItemDetail(selectedChildProduct, item).childProductName }} x {{ selectedChildProduct.quantity || 1 }}
{{ getSelectedItemDetail(selectedChildProduct, item).childVariationName }}
以優惠價加購商品 (最多 {{ addItemQuantity }} 件)
商品存貨不足,未能加入購物車
您所填寫的商品數量超過庫存
{{'products.quick_cart.out_of_number_hint'| translate}}
{{'product.preorder_limit.hint'| translate}}
每筆訂單限購 -1 件
{{'products.quick_cart.quantity_of_stock_hint'| translate : {message: quantityOfStock} }}
物料升級|防霉不積垢|不卡死360°旋轉|韓系生活感色調(奶油/牛油/深綠)
Deareal 以一條 乾淨、安全、柔韌 的特製 PVC 淋浴喉,從根本改善浴室環境, 令每一次沐浴都變得更安心、更享受。
一般金屬淋浴喉因為材質堅硬、縫隙多,加上浴室長期潮濕, 容易成為細菌和霉菌的溫床。Deareal 採用特製柔韌 PVC,做到:
舊式淋浴喉最惱人的地方,就是用幾次之後就開始打結、扭死、卡住不動。 Deareal 採用特別的 360° 旋轉接駁設計:
生活細節變順手,整個沐浴體驗自然升級。
內部採用由內到外共四層結構,比一般淋浴喉更堅固、耐用:
柔軟卻不脆弱,用得久、用得安心。
顏色溫柔、沒有強烈反光感,無論是水泥風、木系、白色系浴室都非常好配搭, 讓日常空間多一分溫度與質感。
柔軟的材質令淋浴喉在 捲起、垂放 的時候更加聽話:
每天進入浴室,視覺也變得更舒服。
每條淋浴喉都附送 Mini 迷你扳手,讓你一個人就能輕鬆更換:
約 2 分鐘就能完成,無需額外工具、無需請人上門。
Deareal 淋浴喉通過多項安全檢測,包含: